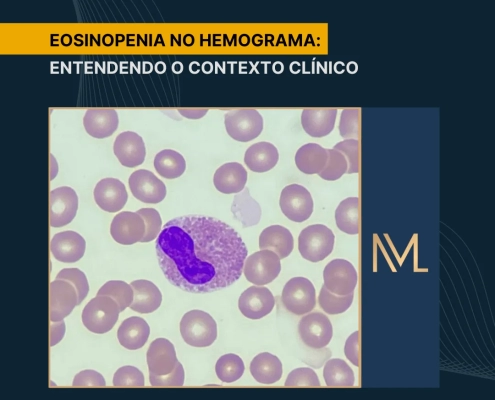

Câncer de Mama: Marcadores Tumorais
O câncer de mama é o tipo mais comum de câncer entre as mulheres em todo o mundo. Além disso, o diagnóstico precoce auxilia na melhoria das taxas de morbimortalidade. Portanto, identificar a doença em estágios iniciais é fundamental…

Hemograma Em Idosos: Alterações Laboratoriais
Nos dias atuais, graças aos avanços na área da saúde e ao aumento da expectativa de vida da população, temos observado um cenário em que as pessoas vivem por um período mais prolongado. Neste artigo, vamos aprofundar a discussão acerca…

Certificação e Acreditação Laboratorial
Atualmente, a garantia da qualidade nos laboratórios clínicos é reconhecida como um pilar fundamental para a confiabilidade dos resultados analíticos e a segurança do paciente, além de contribuir significativamente para a credibilidade…

Tubos de Coleta: Importância da Sequência para Análises Laboratoriais
A análise laboratorial desempenha um papel vital no diagnóstico e tratamento de diversas condições de saúde. No entanto, é comum que tanto profissionais da saúde quanto pacientes subestimem a relevância da ordem adequada dos tubos de…
Eosinopenia No Hemograma: Entendendo o Contexto Clínico
A eosinopenia no hemograma é caracterizada pela redução nos níveis de eosinófilos em comparação aos valores esperados para indivíduos saudáveis da mesma faixa etária.
Geralmente, essa condição não é identificada em exames…

Gestão da Qualidade em Laboratórios de Análises Clínicas
A gestão da qualidade em laboratórios de análises clínicas é um alicerce indispensável para a segurança e efetividade do diagnóstico laboratorial. Os profissionais que atuam nesse ambiente lidam com uma rotina técnica altamente especializada,…

Lipidograma: Avaliação do Perfil Lipídico
O lipidograma, também conhecido como perfil lipídico, é um exame amplamente requisitado em laboratórios clínicos.
Este é composto pela medição do colesterol total e de suas frações — LDL, HDL e VLDL — além dos níveis de…

Cristais da Morte: Importância Clínica
O hemograma é um exame fundamental na rotina hospitalar, pois fornece informações valiosas sobre a saúde do paciente. Embora os métodos automatizados tenham simplificado sua realização, ainda assim é necessário realizar esfregaços…

Controle Interno De Qualidade Em Laboratórios Clínicos
Os laboratórios de análises clínicas ocupam uma posição estratégica no sistema de saúde, sendo pilares essenciais na prevenção, no diagnóstico preciso, na definição terapêutica e no acompanhamento evolutivo das doenças. Essa relevância…

Hemograma na Febre Maculosa
A febre maculosa é uma doença infecciosa, caracterizada por febre aguda e de gravidade variável. Ela é causada por uma bactéria do gênero Rickettsia. No artigo, exploraremos o papel do hemograma no diagnóstico e acompanhamento da febre…
